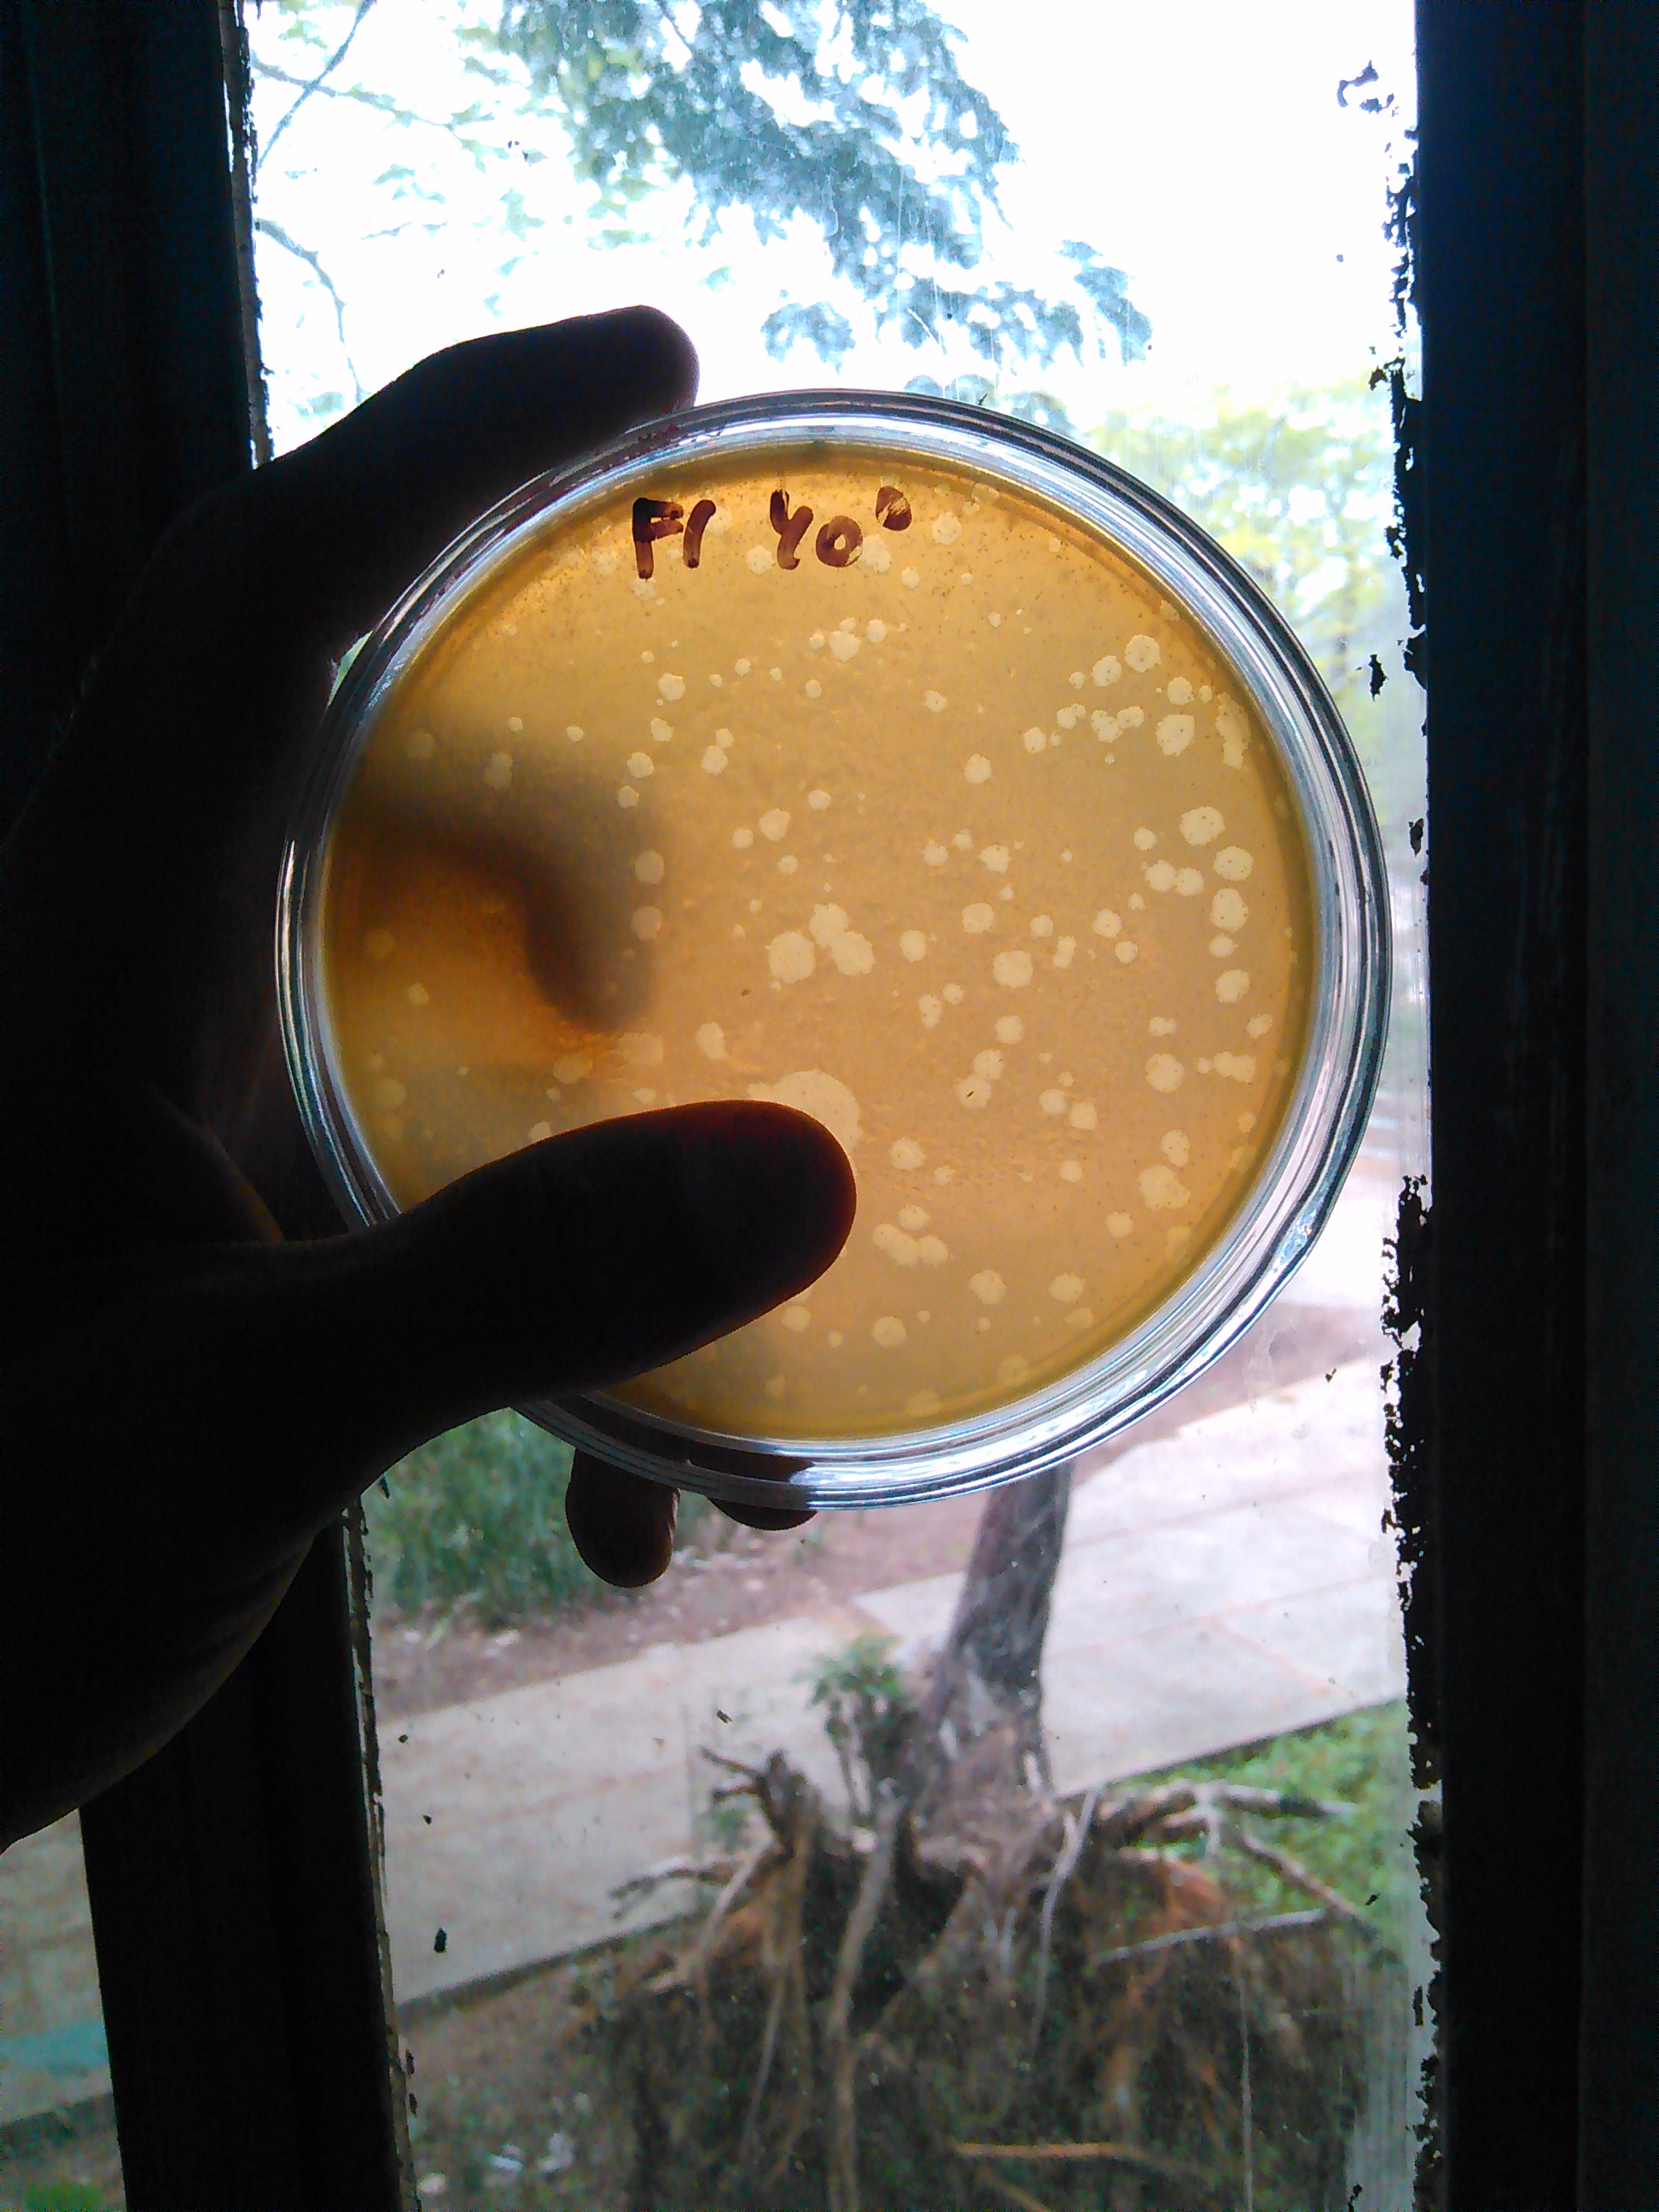
Cover

Frequency of SNPs in the ghrl gene associated with Diabetes Mellitus type-2: a preliminary analysis of the implication of genetic variability on gene therapy with CRISPR/Cas
The gene of ghrelin (ghrl) (3p26-p25) is responsible for the synthesis of a hormone involved in the stimulation of appetite and storage of fat in adipose tissue...
4
7
$0.00